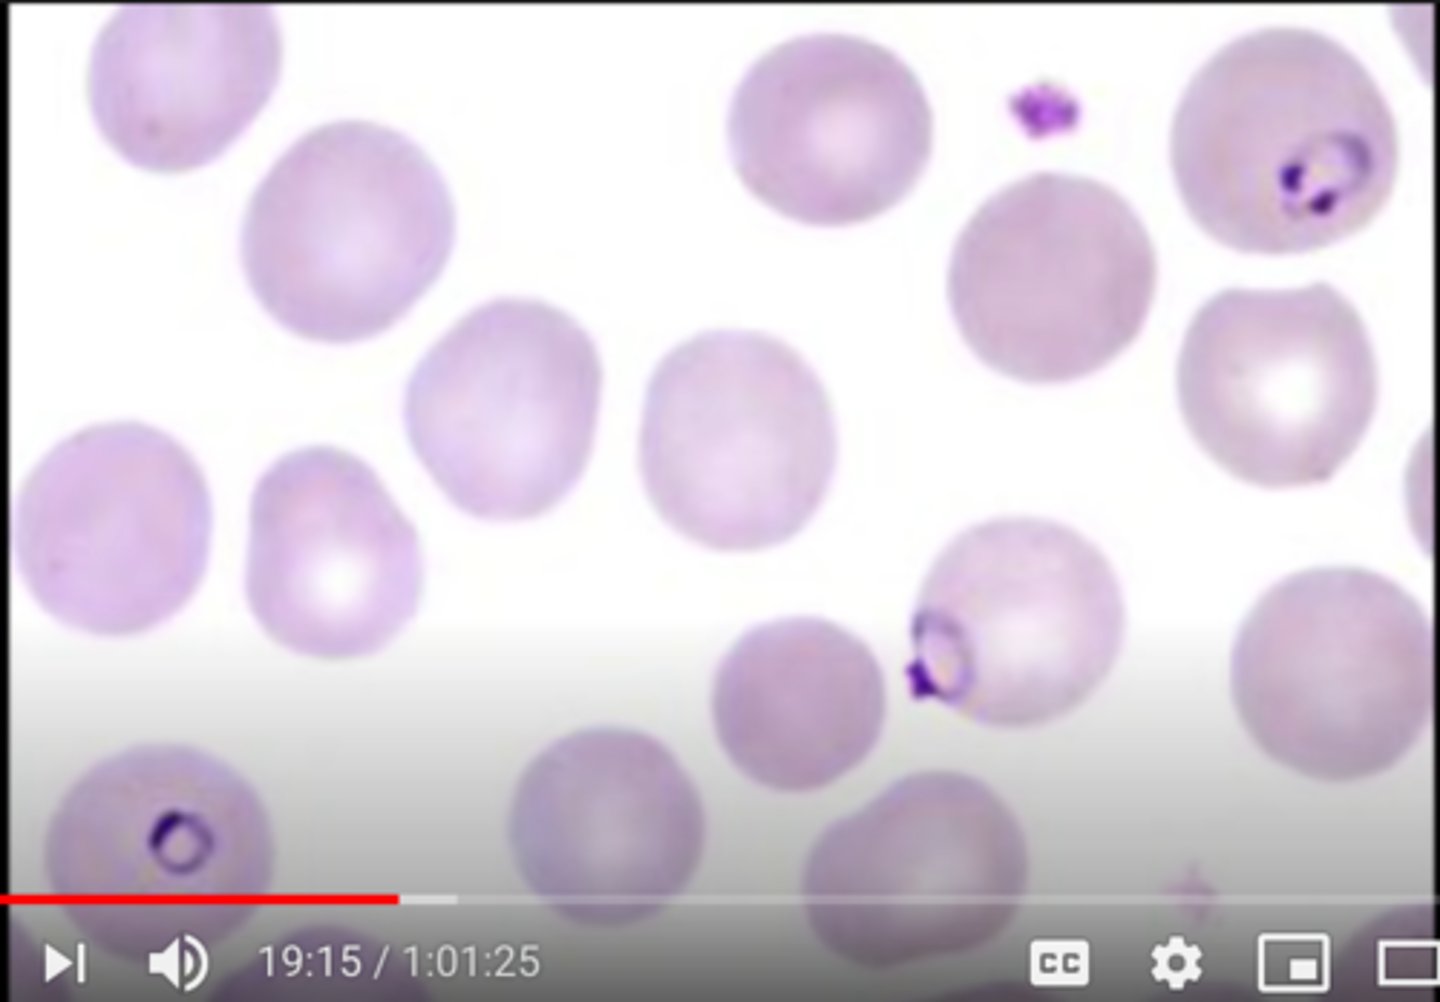
knowt flashcard image

Doctor High Yield Pediatrics
1/205
There's no tags or description
Looks like no tags are added yet.
Name | Mastery | Learn | Test | Matching | Spaced |
|---|
No study sessions yet.
206 Terms
neonate 0-3m old:
most common bugs
empiric tx
GBS
E coli
Listeria
suspect PNA or meningitis--> tx ampicillin and gentamicin
>3m/o:
most common bugs
empiric tx
strep pna
h flu
moraxella
tx vancomycin, ceftriaxone
CSF findings b/w bacterial, viral, and fungal: WBC, glucose, proteins

TB CSF findings
looks like fungal: WBC= lymphocytes, low glucose
TB mengitis imaging findings
basilar enhancement
HSV meningitis imaging findingd
temporal lobe involvement + seizures
if bacterial sinusitis ascends, what CN are affected
CN 3, 4, V1, V2, V6
diphtheria presentation and tx
blue grey membrane on posterior pharynx
no DTAP
tx: diphtheria antitoxin
more pain with ear pulling-- OE or OM?
OE
fluid bubbles behind TM-- tx?
supportive
infected LN-- bug?
staph aureus
u/l v b/l parotitis-- cause?
b/l= mumps
u/l= staph aureus
impetigo tx
mupirocin
erysipelas and cellulitis cause and difference
strep pyogenes
diff:
erysipelas= rapid onset in 1 day w/ very sharp borders (dermal lymphatic infection)
nec fasc + crepitus-- cause
clostridium perfringes
PSGN v IgA nephropathy
PSGN
- start w/ strep
- 2 weeks later: cola colored urine 2/2 glomerular bleeding w/ dysmorphic RBC
IgA nephropathy
- happens w/i 3-5 days after URI
- hematuria
Rubella vs. Measles (Rubeola) differentiation and tx
Maculopapular rash (both start up top and descend down)
rubella-- more joint pain
- TX: supportive
- fetus can get PDA, pulm stenosis
measles-- cough, coryza, conjunctivitis
- TX: vit A
aspergillus key lab finding
eosinophils!!!
likes upper lobes of lung
TB
silicosis
aspergillus
malaria on histo
presentation of toxoplasma for fetus
chorioretinitis
hydrocephalus
intracranial calficications
RMSF rash
rash move from peripheral to center
erlichia presentation
decreased WBC after tick bite
lyme dz presentation
erythema migrans
babesia presentation
evidence of hemolysis
latent v active TB tx
active: rifampin, isoniazid, pyrazinamide, ethambutol
latent: isoniazid x9m if + PPD but - CXR
active TB dx based on PPD findings
15cm+ in regular population
10cm+ in healthcare workers, incarcerated, immigrants, kids <4 y/o
5cm+ in close contact w/ TB pt or if pt has HIV/AIDS
fixed, split S2
ASD
coarctation of aorta tx
prostaglandins
if kid given 100% O2 and PaO2 doesn't rise=
congenital heart defect
does rise= lung problem
transposition of great vessels tx
associated w/?
arterial switch + keep PDA open
associated w/ gestational DM
only cyanotic heart condition w/ LVH
tricuspid atresia
who need ppx abx prior to dental procedures?
hx of congenital heart disease
prosthetic heart valves
previous infective endocarditis
fetus w/ complete heart block-- what does mom have?
lupus
tetralogy of fallot findings in heart and presentation
VSD
pulmonic stenosis
overriding aorta
RVH
tet spells to increase total peripheral resistance
holosystolic murmur ddx
MR, TR, VSD
most common cardiac defect
VSD
laryngomalacia v vascular ring
laryngomalacia= collapsed larynx, p/w inspiratory stridor, worse when supine
vascular ring= caused by anomaly of aortic arch stroking trachea, p/w inspiratory and expiratory stridor, better w/ extension of neck
croup cause
parainfluenza
croup tx
1- cool mist
2- systemic steroids
3- racemic epi (stridor at rest + respiratory distress)
bacterial tracheitis bug
staph aureus
croup advances
atelectasis=
collapsed lung
bronchiolitis cause
RSV
bronchiolitis presentation
nonspecific URI, <2 y/o, progresses to asthma-like presentation w/ tachypnea and crackles
cxr: hyperinflation, atelectasis
tx: supportive
b/l infiltrates on CXR-- what bugs most likely?
mycoplasma, chlamydia, legionella
chlamydia PNA key
buzzword: staccato cough
eos
pertussis tx
macrolides
asthma dx and tx

CF pathophys
CFTR channel actively secretes Cl- into lungs and GI tract, and actively reabsorbs Cl- from sweat. misfolded protein->retained in RER-> dec Cl (and H2O) secretion->inc intracell Cl-> compensate inc Na reab via epi Na channels-> inc H20 reab-> abnrl thick mucus and negative transepi potential diff, bronchiectasis
kid w/ abdominal pain, nausea, bilious vomiting
midgut volvulus
midgut volvulus dx modality
upper GI series
jejunal atresia dx and association
triple bubble sign
maternal cocaine use
duodenal atresia dx and association
double bubble sign
Down's syndrome
intussusception tx
air enema
no barium!!
meckel's diverticulum v intussusception
meckel's w/ painless bleeding
necrotizing enterocolitis presentation
premie baby who feeds too early then later has rectal bleeding
XR: pneumocystis intestinalis (air in intestinal wall)
criggler najjar cause and lab
deficiency in glucornyl transferase --> unconjugated hyperbili
most common nephrotic syndrome, histo?
MCD
histo: podocyte foot process effacement
most common hypercoagulable state in nephrotic syndrome
renal vein thrombosis= sudden onset flank pain
encapsulated organisms mnemonic
please SHiNE MY SKiS
Pseudomonas
Strep pneumo
H flu
Neisseria
E coli
MYcoplasma
Salmonella
Klebsiella
gbS
TTP: mnemonic for symptoms
FAT RN
Fever
Anemia
Thrombocytopenia
Renal
Neuro
too much VW factor= increased plt adhesion--> blocks up arteries --> shistocytes
uremia manifestations
pericarditis
HUS
plt dysfunction
alport syndrome sx
hematuria and deafness
RTA type 1
1 letter= can't excrete H+
kidney stONEs
RTA Type 2
2 letters= Bi
Bicarb
RTA Type 4
4 letters= aldo
hypoaldosterone
*HyperK
posterior urethral valves-- when to suspect? dx?
oligohydramnios
boy who was just born and hasn't urinated
dx: VCUG
high pH kidney stone
proteus= struvite stones
Wernig-Hoffman disease
looks like botulism but has been present since birth
signs of botulism
constipation
dilated pupils
tachycardia
flaccid paralysis
dandy walker
no cerebellum, enlarged 4th ventricle
tuberous sclerosis sx and tx
tx: ACTH
angiomyolipoma= benign renal neoplasm composed of fat, vascular, and smooth muscle

sumatriptan MOA
serotonin agonist
Cytoalbuminologic dissociation
GBS
= high protein in the cerebrospinal fluid without many (usually less than 6) white blood cells
tx for GBS
IVIG and plasmapheresis
Duchenne muscular dystrophy v becker's
duchenne= happens earlier and can't survive
baby only drinking cow milk -->
vit D deficiency
baby only drinking goat milk -->
folate deficiency
vWD labs
increased bleeding time since PLT don't stick
increased PTT
wilms tumor v neuroblastoma
wilms WILL not cross
neuroblastoma will cross w/ dancing eyes and dancing feet and flushing
VACTERL v CHARGE
VACTERL w/ anal atresia
ewing sarcoma dx
onion skinning
w. small round blue cells
osteosarcoma dx
codman's angle and sunburst pattern
osteoid osteoma
lytic bone lesion on bone cortex
CVID labs
low Ab only
SCID labs
low B
low T
low Ab
looks like AIDS
bruton labs
low B cells
XLR inheritance
CGD presentation
no oxidative burst --> Cat+ bugs infxn (S aureus, Escherichia coli, Candida, Klebsiella, Pseudo- monas, Aspergillus)
tx: BMT
chediak higashi
albinism, peripheral neuropathy, neutropenia
↑ Incidence of overwhelming pyogenic infections withS pyogenes, S aureus, and Pneumococcus species
giant granules in neutrophils
rashes that occur on hands
kawasaki KARS
kawasaki dz
coxsackie A
Rickettsia
Syphillis
lupus tx
NSAIDs + hydroxychloroquine
dermatomyositis presentation and association
weakness + grotton's papules + heliotrope rash
elevated CPK
underlying cancer!!
lyme dz <8 y/o-- tx w.?
amoxicillin
cant use doxy because affects teeth
down's syndrome GI associations
duodenal atresia
hirschsprung dz= FTPM + bilious vomiting w.i 48h of life
spondylolysis vs spondylolisthesis
Spondylolysis
- Stress fracture of the pars interarticularis - scotty dog
- Seen in dancers, gymnasts, lifters
Spondylolisthesis
- Vertebral sliding (step-off)
- Seen in dancers and gymnasts
developmental dysplasia of the hip sx and tx
malformed acetabulum w/ clunking hip, asymmetric buttfold
tx: pavlik harness
SCFE sx and tx
epiphysis of femur slips
fat kid, ~12 y/o
tx: surgical pinning
Legg-Calve-Perthes Disease
idiopathic avascular necrosis
tx: PT
septic arthritis v transient synovitis
septic= can't bear weight, systemic sx
transient= no systemic sx, recent URI or diarrhea
red joint-- first step?
aspirate!
50k+ WBC= need abx